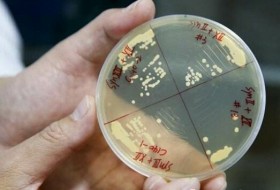

-
2017-03-24 10:26化工
中俄合作研究微生物采油技术 低耗高效且环保从22日召开的上海市科技奖励大会上传来消息,与华东理工大学牟伯中教授长期合作的俄罗斯科学家米哈伊尔·弗拉基米诺维奇·伊万诺夫教授荣获了上海市国际科技合作奖。
-
2017-03-24 10:15医药
安徽智飞生物与上海巴斯德研究所合作研发寨卡病毒疫苗根据协议,巴斯德研究所将按照合同约定完成疫苗工程菌的优化和构建、种子批的建立、并获得检定合格报告等相关工作;双方共同完成寨卡病毒疫苗的临床前研究、申报临床实验、确定临床研究方案及后续相关技术研究工作。智飞龙科马则将按照协议约定及根据进度支付开发经费及报酬,合计4000万元;并对项目开发的疫苗享有生产及销售权利,负责临床实验及研究成果产业化工作。 -
2017-03-24 10:08农业
2017年绿色农药先进制造院士论坛在上虞召开3月22日,“2017年绿色农药先进制造院士论坛”在绍兴上虞召开,10多位院士专家围绕绿色农药发展对话我省农药企业,共同探讨近年来农药绿色制造的最新技术进展和发展趋势。
-
2017-03-24 09:56化工
JACS:全新的人工奇碳二羧酸生物合成途径研究者首先发现大肠杆菌的生物素合成途径中有一个重要的7碳中间体庚二酰-ACP。这条合成途径由BioC对丙二酰-ACP的甲基化起始,然后脂肪酸合酶FAS将两分子的丙二酰甲酯基团相连接,形成庚二酰-ACP甲酯中间体;接着 BioH将甲基酯基团水解从而形成庚二酰基团再通过下游的反应最终生成生物素。研究人员尝试着将途径中的BioH进行阻断,使得FAS可以持续将ACP-甲基酯分子进行延长。同时过表达内源的截短的酰基-ACP硫酯酶‘tesA来产生奇数碳链的单甲基酯分子并继续水解为奇数碳的二羧酸。作者认为该生物合成途径
-
2017-07-14 08:32农业
硫酸粘杆菌素禁用了,金霉素、黄霉素、喹乙醇还远吗?2017年3月22日,农业部起草了《全国遏制动物源细菌耐药行动计划(2017—2020年)(征求意见稿)》,这一次剑指更多的抗生素,如金霉素、黄霉素、喹乙醇等等,先随若南来看看这个条文的主导思想: -
2017-03-19 18:43食品
广西贵港三正酵母生产有限公司开工建设3月15日,坐落港北区港城镇东山村的三正酵母生产有限公司举行开工仪式,同时与市工业和信息化委员会达成战略合作协议,与市港航管理局签署《贵港港中心港区公共货运码头建设项目协议》。 -
2017-03-17 12:45医药
浙江诚意药业在上海证券交易所上市3月15日上午9:30分,随着上海证券交易所内“铛”的一声锣响,浙江诚意药业股份有限公司(简称“诚意药业”,股票代码“603811”)在上海证券交易所上市,成为温州第20家上市公司。
-
2017-03-17 12:41医药
环保限产,原料药价格进入上涨周期2017年7、8月份,维生素C行业有可能出现全面限制供货,经销商预计后续价格上涨到100元/公斤的可能性较大。硫红目前主要生产厂家的产能刚好满足市场需求,已经存在联手提价的空间。 -
2017-03-17 12:27医药
维生素C行业供需形势好转据中国饲料行业信息网日前报道,近一个月来环保督查组进驻京津冀地区严查企业环保问题,近日有VC(维生素C)原粉厂家签单量下降明显,部分VC厂家停报,出现提价意愿,市场关注度增加,成交好转,经销商报价上调。目前饲料级VC原粉报价在52-55元/公斤,比上周五上涨了3元/公斤。 -
2018-12-24 08:44食品
帝斯曼与赢创宣布将投资2亿美元建设最大EPA和DHA发酵工厂近日,荷兰帝斯曼集团和德国赢创工业集团联合宣布他们将联合投资2亿美元用于建设最大生产ω-3脂肪酸(EPA和DHA)的发酵工厂。 将有希望打破目前DHA和EPA的天然提取的供应方式。帝斯曼在海洋生物包括藻类的培养和长期以来的生物技术产业的开发和运营方面有得天独厚的优势,而赢创工业的重点是开发工业生物技术过程,特别是大规模发酵生产氨基酸。
-
2017-03-14 10:58食品
番茄红素:在面包酵母中的生物合成据天津大学生物合成研究团队肖文海研究员介绍,早在2012年初,他们就瞄准了番茄红素的巨大需求,选择食品安全的面包酵母作为生产菌,以合成生物技术为手段,经过近3年的攻关,在2015年底成功获得了第一代高效番茄红素生产菌。 -
2017-03-13 11:04医药
华大基因参与酿酒酵母染色体合成基因修饰的酵母已经用来制作疫苗、药物和特定的化合物,这些新成果的发表意味着化学物质设计定制酵母生命体成为可能,产物范围也将被拓展。随着人工合成酵母的推广应用,必将显著提高其在工业生产、药物制造等方面的效率与质量。
-
2017-03-17 12:31医药
2016年维生素C出口超13万吨 同比增长6%据前瞻数据库数据显示,2016年国内维生素C出口数量为131159吨,同比增长6%;其中12月出口10334吨,同比减少23.8%。
-
2018-10-14 10:10医药
政府助力沙县侨丹复产 L-异亮氨酸生产线预计年产800吨2月19日8时,福建省沙县侨丹实业有限公司车间主任徐福生盼来了再次点燃锅炉的机会。侨丹已有近20年生化领域生产历史。未停产前,侨丹是三明市农业产业化重点龙头企业,从事生物技术以高附加值氨基酸系列产品及菌种培育和技术服务。其中,公司生产的L-苯丙氨酸各项经济技术指标处于全国领先水平,产能位居全国第一、世界第二,国内市场占有率达54%;侨丹还是制定《苯丙氨酸》行业标准第一起草单位。 -
2017-03-10 11:52教育科研
利用CRISPR-dCas9快速优化酿酒酵母代谢途径具体地,他们将这个方法应用于甘油生物合成途径中,最终效价提高了5.7倍。紧接着他们在两个不同菌株背景里利用这个方法调控戊糖磷酸途径,以表明这个方法的便捷性。最终他们识别并缓和了代谢通路瓶颈,使3-去水莽草酸效价提高了7.8倍,并识别出了3个木糖代谢的独特靶标位点。
-
2017-03-08 11:58医药
原料药价格2月月报原料药受益于供给侧改革+持续环保压力,原料药龙头持续受益。 -
2017-03-10 13:34农业
东海药业微生态饲料添加剂生产许可获批开启养殖新时代日前,东海药业6个微生态饲料添加剂生产许可获批,可替代抗生素,增强畜禽、鱼虾免疫力,开启健康养殖和绿色养殖新时代。 -
2017-03-17 12:36医药
2月份主要原料药价格月报维生素品种未来大概率仍将延续分化行情,受环保因素持续影响,预计17年内VC与VK3价格仍有大概率延续自16年年末的增长势头,价格波动上行 -
2017-03-07 12:16展会报道
BIO CHINA 2017上海国际生物发酵展招商已全面启动BIO CHINA 2017(第五届)上海国际生物发酵产品与技术装备展览会将于2017年10月25-27日在中国上海新国际博览中心举办年度盛会。
-
2017-03-07 12:08医药
2012-2016年其他含有头孢菌素的药品进出口数据及发展趋势2016年其他含有头孢菌素的药品进出口额、数量数据,进口、出口其他含有头孢菌素的药品价格、数量统计,海关编码HS30042019进出口总额查询。
-
2017-03-07 12:04医药
2012-2016年庆大霉素及其衍生物、盐进出口数据及趋势2016年庆大霉素及其衍生物、盐进出口额、数量数据,进口、出口庆大霉素及其衍生物、盐价格、数量统计,海关编码HS29419010进出口总额查询。
-
2017-03-04 10:31医药
降脂“神药”他汀在我国市场表现如何?降脂“神药”他汀在我国市场表现如何?
-
2017-03-03 15:30制药
2017世界疫苗大会以“新技术,新疫苗”为主题的第九届世界疫苗大会将于2017年3月29-31日在北京万达嘉华酒店举办。组委会已邀请国际著名专家学者、著名疫苗企业高管、疾病控制部门领导等做专题报告,将围绕疫苗的政策法规、新型疫苗的研发(传染病疫苗、埃博拉疫苗、HPV疫苗、MERS疫苗、AIDS疫苗、癌症疫苗)、疫苗的生产和运输、疫苗的安全性和质量控制等展开技术讨论,并将发布最新研发成果和研发趋势,帮助企业提高研发效率,缩短研发时间,节约研发成本,加快新型疫苗上市步伐。
-
2018-10-14 22:25医药
国家发改委印发 《“十三五”生物产业发展规划》前不久,国家发改委正式印发《“十三五”生物产业发展规划》(下称《规划》),其中提出要构建生物医药新体系,包括新药创制、精准医学、基因技术、细胞工程、影像信息库网络等将成为未来关注的重点。对此,中国医药生物技术协会秘书长吴朝晖建议,生物医药企业要把握机遇,加速转型升级,集中力量整合资源、做大做强。 -
2017-03-03 11:32农业
伊品生物接受上市辅导 股票尚未正式在股转挂牌公开转让伊品生物发布公告称,公司于2017年2月8日向中国证监会宁夏监管局报送了上市辅导备案材料,已获受理,目前公司正在接受九州证券的辅导。 -
2017-03-03 11:38制药
医药大咖齐聚菏泽高新区 为生物医药发展建言献策2月28日—3月1日,中国生物医药及大健康产业高峰论坛在菏泽高新区举行,来自全国多个省市的医药界专家、代表齐聚一堂,为全市生物医药产业的发展建言献策,并就“双创时代背景下生物医药及大健康产业的未来”进行主题对话,为全市生物医药产业今后的发展方向提供了建设性的意见。
-
2017-03-03 10:09化工
“中国石化微生物采油重点实验室技术委员会第三次会议”在胜利油田召开2月21日,“中国石化微生物采油重点实验室技术委员会第三次会议”在胜利油田石油工程技术研究院召开。来自中国石化、胜利油田、国内各高校、科研院所等约20家单位的50余专家和领导参加会议。 -
2017-03-02 15:12医药
东药三年改革 “家底”逆势增长2016年,东北制药集团股份有限公司全年实现销售收入56.7亿元,缴纳税金2.65亿元,同比增长70%;实现经营性利润2800万元。三年来,东北制药总资产由75.5亿元,上升到97.6亿元。 -
2017-03-02 10:34农业
1月赖氨酸、苏氨酸出口量双增,蛋氨酸进口量创新高2016年全球饲料产量首次超过10亿吨,同比增长3.7%,饲料厂家从3241家降到30090家,同比下降7%。
-
2019-06-17 21:15医药
头孢菌素类抗生素市场分析(附Top10企业)头孢菌素又称先锋霉素,是一类广谱半合成抗生素,第一个头孢菌素于 20 世纪 60 年代问世,目前上市品种已达 60 余种。据中康CMH监测数据显示,2015年度全国抗生素销售总额为1864.3 亿元,其中头孢菌素类销售额为1128.8亿元,占有60.5%的市场比重,市场规模同比增长9.7%,可见头孢菌素类在抗生素市场地位之重。
发酵工业网手机版
打开微信右上角添加朋友中搜索公众号“发酵工业”,关注即可随时随地使用发酵工业服务。发酵工业微信更省心!






